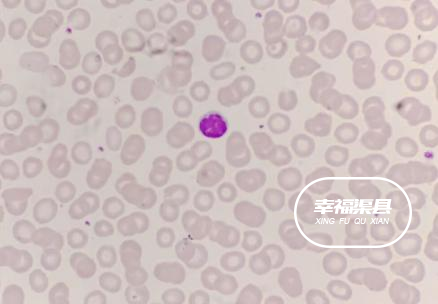

“上高速一看,全是聪明人”
2024-9-30
小言言
来自四川
幸福渠县
9月30日
国庆假期的前一天
为了错峰出行
不少人选择连夜出发
上路了才发现
全是“放假聪明人”
从9月29日到9月30日凌晨
不少网友在各个社交平台晒出
高速多个路段的堵车视频
9月30日,网友为避免堵车提前出发,发现凌晨1点“高速如停车场”。
堵车时,你会选择开窗透气吗?研究发现,交通拥堵时聚集拥堵区的污染物含量远高于移动的汽车。汽车减速、挂挡、起步、加速时会大量燃烧汽油,此时车间距较小,空气中可吸入颗粒物是平时29倍。且堵车时行车缓慢,汽车排出的污染物在空气中长时间累积,比平时高40%。
(综合@四川观察、海客新闻、大众新闻·齐鲁壹点、@生命时报、网友评论等)
本贴来自网友发表,其真实性和合法性由发贴人自行负责,不代表本网站的观点和立场,如存在侵权问题,请与本网站联系!






 游客
游客